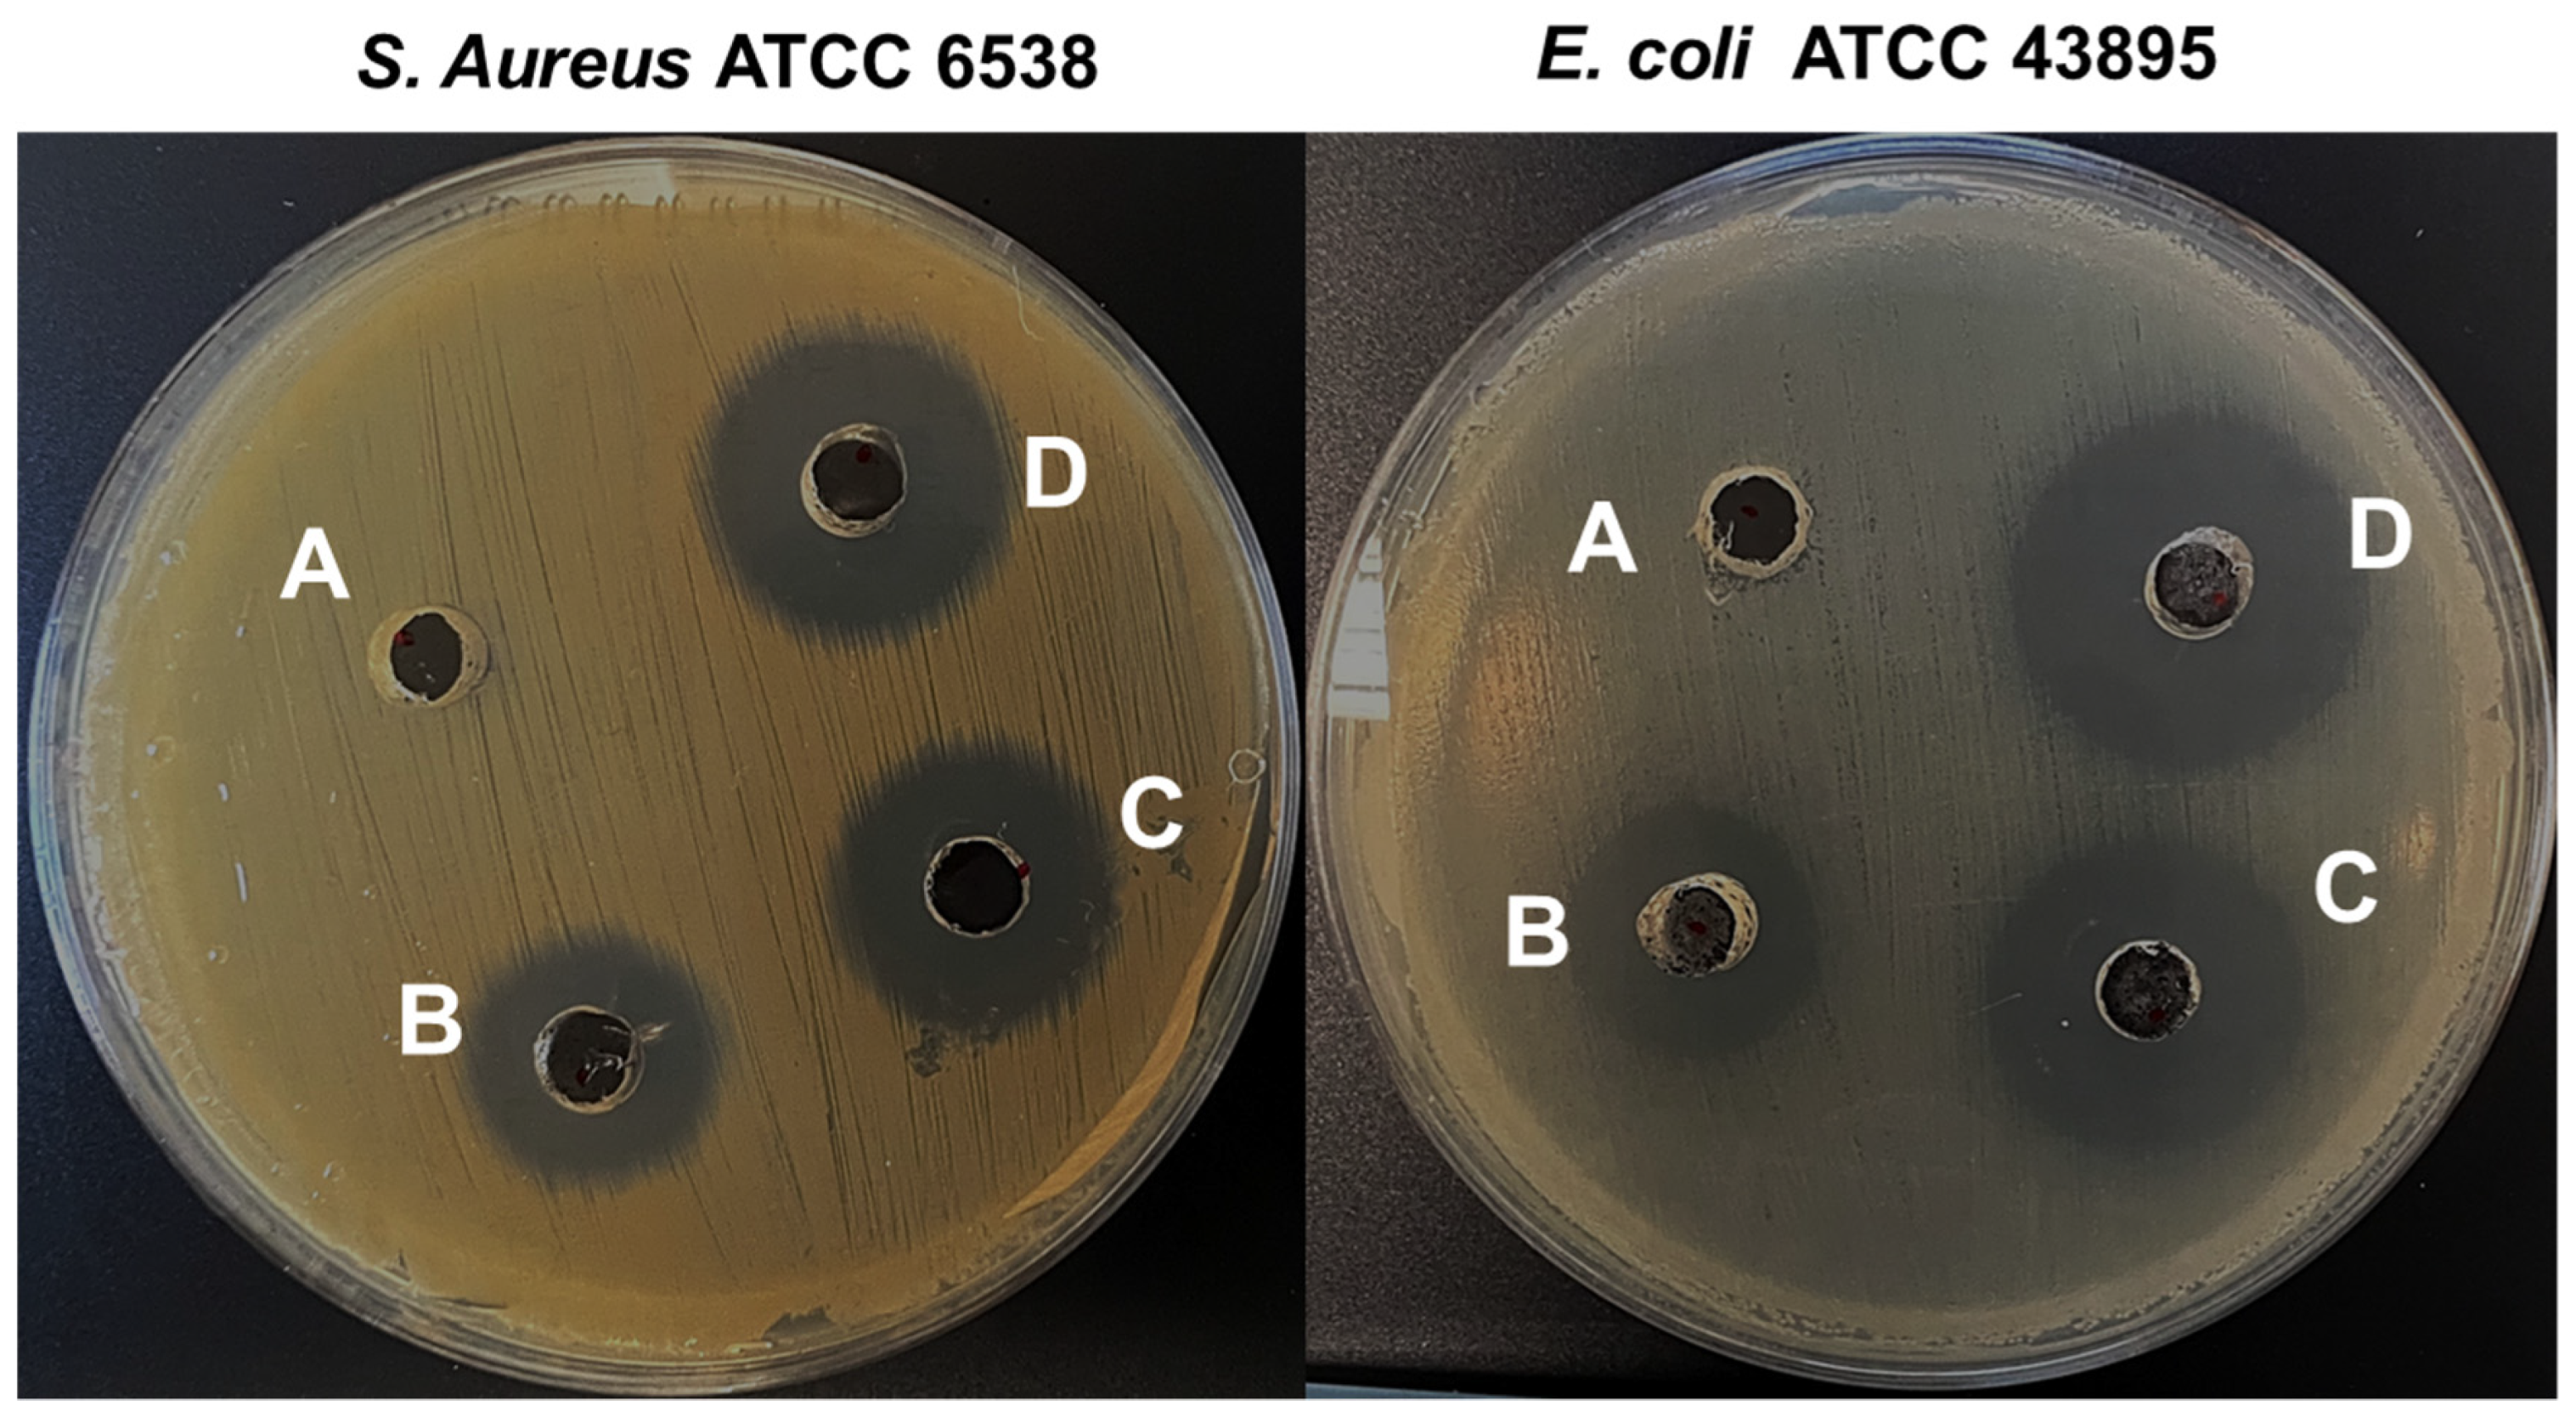
Materials 16 00217 g010 Materials 16 00217 g010

One Pot Synthesis of Copper Oxide Nanoparticles for Efficient Antibacterial Activity
Abstract
1. Introduction
2. Materials and Methods
2.1. Materials
2.2. Preparation of Apple Peel Extract
2.3. Preparation of CuO NPs
2.4. Antibacterial Activity
2.4.1. In-Vitro Antibacterial Efficacy
2.4.2. Antibiofilm Potency of CuO NPs against Bacterial Pathogens
2.4.3. Antibiofilm Potency of CuO NPs against Bacterial Pathogens
2.5. Instruments Used
3. Results and Discussion
3.1. Analysis of Bio-Reduced CuO NPs by DRS
3.2. Analysis of Bio-Reduced CuO NPs by FT-IR Spectrum
3.3. Analysis of Bio-Reduced CuO NPs by Raman Spectrum
3.4. Analysis of Bio-Reduced CuO NPs by XRD
3.5. Analysis of Bio-Reduced CuO NPs by FE-SEM
3.6. Analysis of Bio-Reduced CuO NPs by HR-TEM
3.7. Analysis of Bio-Reduced CuO NPs by XPS
3.8. Analysis of Bio-Reduced CuO NPs by TG/DTA
3.9. Analysis of Bio-Reduced CuO NPs by BET Surface Area
3.10. A Probable Mechanism of Bio-Reduced CuO NPs
3.11. Antibacterial Efficacy of Bio-Reduced CuO NPs
3.12. Antibiofilm Potency of Bio-Reduced CuO NPs against E. coli and S. aureus
4. Conclusions
Supplementary Materials
Author Contributions
Funding
Institutional Review Board Statement
Informed Consent Statement
Data Availability Statement
Conflicts of Interest
References
- Myrna, R.-B.; Nadja, M.M.-L.; Carla, M.R.-Q.; Ana, L.V.-A.; Felix, R.R.-V.; Oscar, J.P.-P. Single Step Microwave Assisted Synthesis and Antimicrobial Activity of Silver, Copper and Silver-Copper Nanoparticles. J. Mater. Sci. Chem. Eng. 2020, 8, 13–29. [Google Scholar]
- CDC. Annual Summaries of Foodborne Outbreaks|Foodborne Outbreak Surveillance System. Food Safety. 2017. Available online: https://www.cdc.gov/fdoss/annual-reports/index.html (accessed on 31 December 2017).
- CDC. Foodborne Germs and Illness. 2020. Available online: https://www.cdc.gov/foodsafety/foodborne-germs.html (accessed on 31 December 2020).
- Beyth, N.; Houri-Haddad, Y.; Domb, A.; Khan, W.; Hazan, R. Alternative Antimicrobial Approach: Nano-Antimicrobial Materials. Evid.-Based Complement. Altern. Med. 2015, 2015, 246012. [Google Scholar] [CrossRef] [PubMed]
- Das, B.; Dash, S.K.; Mandal, D.; Ghosh, T.; Chattopadhyay, S.; Tripathy, S. Green Synthesized Silver Nanoparticles Destroy Multidrug Resistant Bacteria via Reactive Oxygen Species Mediated Membrane Damage. Arab. J. Chem. 2017, 10, 862–876. [Google Scholar] [CrossRef]
- Sharif, Z.; Mustapha, F.J.Y. Revisión de métodos de preservación y conservantes naturales para extender la longevidad de los alimentos. Ing. Quim. 2017, 19, 145–153. [Google Scholar]
- Molkenova, A.; Sarsenov, S.; Atabaev, S.; Khamkhash, L.; Atabaev, T.S. Hierarchically-structured hollow CuO microparticles for efficient photo-degradation of a model pollutant dye under the solar light illumination. Environ. Nanotechnol. Monit. Manag. 2021, 16, 100507. [Google Scholar] [CrossRef]
- Ambardekar, V.; Sahoo, S.; Srivastava, D.K.; Majumder, S.B.; Bandyopadhyay, P.P. Plasma sprayed CuO coatings for gas sensing and catalytic conversion applications. Sens. Actuators B 2021, 331, 129404. [Google Scholar] [CrossRef]
- Vasantharaj, S.; Sathiyavimal, S.; Senthilkumar, P.; Oscar, F.L.; Pugazhendhi, A. Biosynthesis of iron oxide nanoparticles using leaf extract of Ruellia tuberosa: Antimicrobial properties and their applications in photocatalytic degradation. J. Photochem. Photobiol. B 2019, 192, 74–82. [Google Scholar] [CrossRef]
- Pramanika, A.; Lahaa, D.; Chattopadhyay, S.; Dash, S.; Roy, S.; Pramanik, P.; Karmakar, P. Targeted delivery of chitosan-Folic acid coated “copper carbonate” nanoparticle to cancer cells in-vivo. Toxicol. Res. 2015, 4, 1604–1612. [Google Scholar] [CrossRef]
- Laha, D.; Pramanik, A.; Maity, J.; Mukherjee, A.; Pramanik, P.; Karmakar, P. Interplay between autophagy and apoptosis mediated by copper oxide nanoparticles in human breast cancer cells MCF7. Biochim. Biophys. Acta 2014, 1840, 1–9. [Google Scholar] [CrossRef]
- Maqbool, Q.; Iftikhar, S.; Nazar, M.; Abbas, F.; Saleem, A.; Hussain, T.; Kausar, R.; Anwaar, S.; Jabeen, N. Green fabricated CuO nanobullets via Olea europaea leaf extract shows auspicious antimicrobial potential. IET Nanobiotechnol. 2017, 11, 463–468. [Google Scholar] [CrossRef]
- Mohammed, W.M.; Mubark, T.H.; Al-Haddad, R.M.S. Effect of CuO nanoparticles on antimicrobial activity prepared by sol-gel method. Int. J. Appl. Eng. Res. Dev. 2018, 13, 10559–10562. [Google Scholar]
- Akhavan, O.; Ghaderi, E. Cu and CuO nanoparticles immobilized by silica thin films as antibacterial materials and photocatalysts. Surf. Coat. Technol. 2010, 205, 207–213. [Google Scholar] [CrossRef]
- Heinlaan, M.; Ivask, A.; Bilnova, I.; Dubourguier, H.C.; Kahru, A. Toxicity of nanosized and bulk ZnO, CuO and TiO2 to bacteria Vibrio fischeri and crustaceans Daphnia magna and Thamnocephalusplatyurus. Chemosphere 2008, 71, 1308–1316. [Google Scholar] [CrossRef] [PubMed]
- Akintelu, S.A.; Folorunso, A.S.; Folorunso, F.A.; Oyebamiji, A.K. Green synthesis of copper oxide nanoparticles for biomedical application and environmental remediation. Heliyon 2020, 6, e04508. [Google Scholar] [CrossRef] [PubMed]
- Rania, D.; Rabah, A.; Mamadou, T.; Christine, M.; Andrei, K. Antibacterial activity of ZnO and CuO nanoparticles against gram positive and gram negative strains. Mater. Sci. Eng. C 2019, 104, 109968. [Google Scholar]
- Ameer, A.; Arham, S.A.; Oves, M.; Khan, M.S.; Adnan, M. Size-dependent antimicrobial properties of CuO nanoparticles against Gram-positive and -negative bacterial strains. Int. J. Nanomed. 2012, 7, 3527–3535. [Google Scholar]
- Hina, Q.; Sumbul, R.; Dushyant Kumar, C.; Ashok Kumar, T.; Vikramaditya, U. Green Synthesis, Characterization and Antimicrobial Activity of Copper Oxide Nanomaterial Derived from Momordica charantia. Int. J. Nanomed. 2020, 15, 2541–2553. [Google Scholar]
- Jeronsia, J.E.; Joseph, L.A.; Vinosha, P.A.; Mary, A.J.; Das, S.J. Camellia sinensis leaf extract mediated synthesis of copper oxide nanostructures for potential biomedical applications. Mater. Today Proc. 2019, 8, 214–222. [Google Scholar] [CrossRef]
- Koupaei, M.H.; Shareghi, B.; Saboury, A.A.; Davar, F.; Semnani, A.; Evini, M. Green synthesis of zinc oxide nanoparticles and their effect on the stability and activity of proteinase K. RSC Adv. 2016, 6, 42313–42323. [Google Scholar] [CrossRef]
- Awwad, A.M.; Albiss, B.A.; Salem, N.M. Antibacterial activity of synthesized copper oxide nanoparticles using malva sylvestris leaf extract. SMU Med. J. 2015, 2, 91–101. [Google Scholar]
- Pugazhendhi, A.; Kumar, S.S.; Manikandan, M.; Saravanan, M. Photocatalytic properties and antimicrobial efficacy of Fe doped CuO nanoparticles against the pathogenic bacteria and fungi. Microb. Pathog. 2018, 122, 84–89. [Google Scholar] [CrossRef]
- Vasantharaj, S.; Sathiyavimal, S.; Saravanan, M.; Senthilkumar, P.; Gnanasekaran, K.; Shanmugavel, M.; Manikandan, E.; Pugazhendhi, A. Synthesis of ecofriendly copper oxide nanoparticles for fabrication over textile fabrics: Characterization of antibacterial activity and dye degradation potential. J. Photochem. Photobiol. B Biol. 2019, 191, 143–149. [Google Scholar] [CrossRef]
- Yang, N.; Weihong, L.; Hao, L. Biosynthesis of Au nanoparticles using agricultural waste mango peel extract and its in vitro cytotoxic effect on two normal cells. Mater. Lett. 2014, 134, 67–70. [Google Scholar] [CrossRef]
- Yang, B.; Qi, F.; Tan, J.; Yu, T.; Qu, C. Study of green synthesis of ultrasmall gold nanoparticles using Citrus sinensis peel. Appl. Sci. 2019, 9, 2423. [Google Scholar] [CrossRef]
- Gangapuram, B.R.; Bandi, R.; Alle, M.; Dadigala, R.; Kotu, G.M.; Guttena, V. Microwave assisted rapid green synthesis of gold nanoparticles using Annona squamosa L peel extract for the efficient catalytic reduction of organic pollutants. J. Mol. Struct. 2018, 1167, 305–315. [Google Scholar] [CrossRef]
- Mahmoud, N.; Fatemeh, G.; Zahra, I.; Mohammad, S. Recent developments in the biosynthesis of Cu-based recyclable nanocatalysts using plant extracts and their application in the chemical reactions. Chem. Rec. 2019, 19, 601–643. [Google Scholar]
- He, X.; Liu, R.H. Phytochemicals of Apple Peels: Isolation, Structure Elucidation, and Their Antiproliferative and Antioxidant Activities. J. Agric. Food Chem. 2008, 56, 9905–9910. [Google Scholar] [CrossRef]
- Mohamed, A.A.; Abu-Elghait, M.; Ahmed, N.E.; Salem, S.S. Eco-friendly mycogenic synthesis of ZnO and CuO nanoparticles for in-vitro antibacterial, antibiofilm, and antifungal applications. Biol. Trace Elem. Res. 2021, 199, 2788–2799. [Google Scholar] [CrossRef]
- Kim, Y.-G.; Lee, J.-H.; Raorane, C.J.; Oh, S.T.; Park, J.G.; Lee, J. Herring Oil and Omega Fatty Acids Inhibit Staphylococcus aureus Biofilm Formation and Virulence. Front. Microbiol. 2018, 9, 1241. [Google Scholar] [CrossRef]
- Junfei, F.; Yimin, X. Investigation of optical absorption and photothermal conversion characteristics of binary CuO/ZnO nanofluids. RSC Adv. 2022, 7, 56023–56033. [Google Scholar]
- Mohammad, S.D.; Mostafa, Z.M. Experimental study of water-based CuO nanofluid flow in heat pipe solar collector. J. Therm. Anal. Calorim. 2019, 137, 2061–2072. [Google Scholar]
- Maji, S.K.; Mukherjee, N.; Mondal, A.; Adhikary, B.; Karmakar, B. Chemical synthesis of mesoporous CuO from a single precursor: Structural, optical and electrical properties. J. Solid State Chem. 2010, 183, 1900–1904. [Google Scholar] [CrossRef]
- Lin, H.-H.; Wang, C.-Y.; Shih, H.C.; Chen, J.-M.; Hsieh, C.-T. Characterizing well-ordered CuO nanofibrils synthesized through gas-solid reactions. J. Appl. Phys. 2004, 95, 5889–5895. [Google Scholar] [CrossRef]
- Kaur, M.; Muthe, K.P.; Despande, S.K.; Shipra, C.; Singh, J.B.; Neeika, V.; Gupta, S.K.; Yakh-mi, J.V. Growth and branching of CuO nanowires by thermal oxidation of copper. J. Cryst. Growth 2006, 289, 670–675. [Google Scholar] [CrossRef]
- Anita, S.E.; Dae, J.K. Synthesis and characterization of CuO nanowires by a simple wet chemical method. Nanoscale Res. Lett. 2012, 7, 70. [Google Scholar]
- Nyquist, R.A.; Kagel, R.O. Infrared Spectra of Inorganic Compounds; Academic Press: New York, NY, USA; London, UK, 1997; Volume 220. [Google Scholar]
- Kliche, K.; Popovic, Z.V. Far-infrared spectroscopic investigations on CuO. Phys. Rev. B 1990, 42, 10060–10066. [Google Scholar] [CrossRef]
- Benhammada, A.; Trache, D.; Chelouche, S.; Mezroua, A. Catalytic Effect of green Cu2O nanoparticles on the thermal decomposition kinetics of ammonium perchlorate. Z. Anorg. Allg. Chem. 2021, 647, 312–325. [Google Scholar] [CrossRef]
- Karthikeyan, B. Raman spectral probed electron–phonon coupling and phonon lifetime properties of Ni-doped CuO nanoparticles. Appl. Phys. A 2021, 127, 205. [Google Scholar] [CrossRef]
- Angeline Mary, A.P.; Thaminum Ansari, A.; Subramanian, R. Sugarcane juice mediated synthesis of copper oxide nanoparticles, characterization and their antibacterial activity. J. King Saud Univ. Sci. 2019, 31, 1103–1114. [Google Scholar] [CrossRef]
- Saad, N.A.; Dar, M.H.; Ramya, E.; Naraharisetty, S.R.G.; Narayana Rao, D. Saturable and reverse saturable absorption of a Cu2O-Ag nanoheterostructure. J. Mater. Sci. 2019, 54, 188–199. [Google Scholar] [CrossRef]
- Nagajyothi, P.; Muthuraman, P.; Sreekanth, T.; Kim, D.H.; Shim, J. Green synthesis: In-vitro anticancer activity of copper oxide nanoparticles against human cervical carcinoma cells. Arab. J. Chem. 2017, 10, 215–225. [Google Scholar] [CrossRef]
- Chandan, T.; Indranirekha, S.; Moushumi, H.; Manash, R.D. Reduction of aromatic nitro compounds catalyzed by biogenic CuO nanoparticles. RSC Adv. 2014, 4, 53229–53236. [Google Scholar]
- Ehsan, A.; Mohammad, H.; Reza, S.; Maryam, S. Copper plasmon-induced Cu-doped ZnO-CuO double-nanoheterojunction: In-situ combustion synthesis and pho-to-decontamination of textile effluents. Mater. Res. Bull. 2020, 129, 110880. [Google Scholar]
- Masoud, M.; Abdullah, I.; Reza, I. A performance study on the electrocoating process with CuZnAl nanocatalyst for a methanol steam reformer: The effect of time and voltage. RSC Adv. 2016, 6, 25934–25942. [Google Scholar]
- Qiuli, Z.; Zhimao, Y.; Bingjun, D.; Xinzhe, L.; Yingjuan, G. Preparation of copper nanoparticles by chemical reduction method using potassium borohydride. Trans. Nonferrous Met. Soc. China 2010, 20, s240–s244. [Google Scholar]
- Cornell, R.M.; Schwertmann, U. The Iron Oxides Structure, Properties, Reactions Occurrences and Uses; Wiley-VCH: Weinheim, Germany, 1996. [Google Scholar]
- Ismail, M.; Khan, M.I.; Khan, S.B.; Khan, M.A.; Akhtar, K.; Asiri, A.M. Green synthesis of plant supported Cu single bond Ag and Cu single bond Ni bimetallic nanoparticles in the reduction of nitrophenols and organic dyes for water treatment. J. Mol. Liqs. 2018, 260, 78–91. [Google Scholar] [CrossRef]
- Issaabadi, Z.; Nasrollahzadeh, M.; Sajadi, S.M. Green synthesis of the copper nanoparticles supported on bentonite and investigation of its catalytic activity. J. Clean. Prod. 2017, 142, 3584–3591. [Google Scholar] [CrossRef]
- Karthik, K.V.; Raghu, A.V.; Reddy, K.R.; Ravishankar, R.; Sangeeta, M.; Nagaraj, P.S.; Reddy, C.V. Green synthesis of Cu-doped ZnO nanoparticles and its application for the photocatalytic degradation of hazardous organic pollutants. Chemosphere 2022, 287, 132081. [Google Scholar] [CrossRef]
- Yadav, D.; Subodh, S.K. Awasthi, Recent advances in the design, synthesis and catalytic applications of triazine-based covalent organic polymers. Mater. Chem. Front. 2022, 6, 1574–1605. [Google Scholar] [CrossRef]
- Arif Khan, M.; Nafarizal, N.S.; Mohd, K.A.; Chin, F.S. Surface Study of CuO Nanopetals by Advanced Nanocharacterization Techniques with Enhanced Optical and Catalytic Properties. Nanomat 2020, 10, 1298. [Google Scholar] [CrossRef]
- Shinde, S.K.; Dubal, D.P.; Ghodake, G.S.; Fulari, V.J. Hierarchical 3D-flower-like CuO nanostructure on copper foil for supercapacitors. RSC Adv. 2014, 5, 4443–4447. [Google Scholar] [CrossRef]
- Molazemhosseini, A.; Magagnin, L.; Vena, P.; Liu, C.C. Single-Use Nonenzymatic Glucose Biosensor Based on CuO Nanoparticles Ink Printed on Thin Film Gold Electrode by Micro-Plotter Technology. J. Electroanal. Chem. 2017, 789, 50–57. [Google Scholar] [CrossRef]
- Vaseem, M.; Hong, A.R.; Kim, R.T.; Hahn, Y.B. Copper Oxide Quantum Dot Ink for Inkjet-Driven Digitally Controlled High Mobility Field Effect Transistors. J. Mater. Chem. C 2013, 1, 2112–2120. [Google Scholar] [CrossRef]
- Manjari, G.; Saran, S.; Arun, T.; Vijaya Bhaskara Rao, A.; Suja, P.D. Catalytic and recyclability properties of phytogenic copper oxide nanoparticles derived from Aglaia elaeagnoidea flower extract. J. Saudi. Chem. Soc. 2017, 21, 610–618. [Google Scholar] [CrossRef]
- Lakshmi, K.; Revathi, S. A facile route to synthesize CuO sphere-like nanostructures for supercapacitor electrode application. J. Mater. Sci. Mater. Electron. 2020, 31, 21528–21539. [Google Scholar]
- Manoj, D.; Saravanan, R.; Santhanalakshmi, J.; Agarwal, S.; Gupta, V.K.; Boukherroub, R. Towards green synthesis of monodisperse Cu nanoparticles: An efficient and high sensitive electrochemical nitrite sensor. Sens. Actuators B 2018, 266, 873–882. [Google Scholar] [CrossRef]
- Mugundan, A.; Rajamannan, B.; Viruthagiri, G.; Shanmugam, N.; Gobi, R.; Praveen, P. Synthesis and characterization of undoped and cobalt-doped TiO2 nanoparticles via sol–gel technique. Appl. Nanosci. 2015, 5, 449–456. [Google Scholar] [CrossRef]
- Govindaraj, R.; Pandian, S.M.; Ramasamy, P.; Mukhopadhyay, S. Sol–gel synthesized mesoporous anatase titanium dioxide nanoparticles for dye sensitized solar cell (DSSC) applications. Bull. Mater. Sci. 2015, 38, 291–296. [Google Scholar] [CrossRef]
- Manikandan, B.; Rita, J. Impact of Ni metal ion concentration in TiO2 nanoparticles for enhanced photovoltaic performance of dye sensitized solar cell. Mater. Sci. Mater. Electron. 2021, 32, 5295–5308. [Google Scholar]
- Shamaila, S.; Sajjad, A.K.L.; Farooqi, S.A.; Jabeen, N.; Majeed, S.; Farooq, I. Advancements in nanoparticle fabrication by hazard free eco-friendly green routes. Appl. Mater. Today 2016, 5, 150–199. [Google Scholar] [CrossRef]
- Foad, B.; Sajjad, S.; Mohammad, B.; Feisal, K. Biofabrication of highly pure copper oxide nanoparticles using wheat seed extract and their catalytic activity: A mechanistic approach. Green Process. Synth. 2019, 8, 691–702. [Google Scholar]
- Sutradhar, P.; Debnath, N.; Saha, M. Microwave-assisted rapid synthesis of alumina nanoparticles using tea, coffee and triphala extracts. Adv. Manuf. 2013, 1, 357–361. [Google Scholar] [CrossRef]
- Raveendran, P.; Fu, J.; Wallen, S.L. Completely “green” synthesis and stabilization of metal nanoparticles. J. Am. Chem. Soc. 2003, 125, 13940–13941. [Google Scholar] [CrossRef] [PubMed]
- Koopi, H.; Buazar, F. A novel one-pot biosynthesis of pure alpha aluminum oxide nanoparticles using the macroalgae Sargassum ilicifolium A green marine approach. Ceram. Int. 2018, 44, 8940–8945. [Google Scholar] [CrossRef]
- Sathya, S.; Murthy, P.S.; Devi, V.G.; Das, A.; Anandkumar, B.; Sathyaseelan, V.S.; Doble, M.; Venugopalan, V.P. Antibacterial and cytotoxic assessment of poly (methyl methacrylate) based hybrid nanocomposites. Mater. Sci. Eng. C 2019, 100, 886–896. [Google Scholar] [CrossRef]
- Nabila, M.I.; Kannabiran, K. Biosynthesis, characterization and antibacterial activity of copper oxide nanoparticles (CuO NPs) from actinomycetes. Biocatal. Agric. Biotechnol. 2018, 15, 56–62. [Google Scholar] [CrossRef]
- Rudramurthy, G.R.; Swamy, M.K.; Sinniah, U.R.; Ghasemzadeh, A. Nanoparticles: Alternatives against drug-resistant pathogenic microbes. Molecules 2016, 21, 836. [Google Scholar] [CrossRef]
- Logpriya, S.; Bhuvaneshwari, V.; Vaidehi, D.; SenthilKumar, R.P.; Nithya Malar, R.S.; Pavithra Sheetal, B.; Amsaveni, R.; Kalaiselvi, M. Preparation and characterization of ascorbic acid-mediated chitosan–copper oxide nanocomposite for anti-microbial, sporicidal and biofilm-inhibitory activity. J. Nanostruct. Chem. 2018, 8, 301–309. [Google Scholar] [CrossRef]
- Tulinska, J.; Mikusova, M.L.; Liskova, A.; Busova, M.; Masanova, V.; Uhnakova, I.; Rollerova, E.; Alacova, R.; Krivosikova, Z.; Wsolova, L.; et al. Copper Oxide Nanoparticles Stimulate the Immune Response and Decrease Antioxidant Defense in Mice After Six-Week Inhalation. Front. Immunol. 2022, 13, 874253. [Google Scholar] [CrossRef]
- Grigore, M.E.; Biscu, E.R.; Holban, A.M.; Gestal, M.C.; Grumezescu, A.M. Methods of Synthesis, Properties and Biomedical Applications of CuO Nanoparticles. Pharmaceuticals 2016, 9, 75. [Google Scholar] [CrossRef]
- Boliang, B.; Sivakumar, S.; Vaitheeswaran, D.; Muniasamy, S.; Naiyf, S.A.; Barathi, S.; Vinod, S.U.; Balasubramanian, M.G. Biosynthesized copper oxide nanoparticles (CuO NPs) enhances the anti-biofilm efficacy against K. pneumoniae and S. aureus. J. King Saud Uni. Sci. 2022, 34, 102120. [Google Scholar]

| Material | Surface Area (m²/g) | Pore Volume (m²/g) | Pore Size (nm) | |||
|---|---|---|---|---|---|---|
| t-Plot Micropore Volume | BJH Adsorption Cumulative Volume of Pores | BJH Desorption Cumulative Volume of Pores | BJH Adsorption Average Pore Diameter (4V/A) | BJH Desorption Average Pore Diameter (4V/A) | ||
| CuO NPs | 31.8240 | 0.005294 | 0.255223 | 0.251015 | 42. 44 | 39.19 |
| Name of the Bacterial Strains | Zone of Inhibition (mm) | |||
|---|---|---|---|---|
| Conc. of CuO NPs (µg/mL) | ||||
| 300.0 | 200.0 | 100.0 | 0 | |
| S. aureus | 26.0 ± 1.1 | 23.0 ± 1.3 | 19.0 ± 0.9 | ND |
| E. coli | 29.0 ± 2.3 | 26.0 ± 0.8 | 20.0 ± 0.5 | ND |
| Bacterial Strains | Biofilm Biomass (µm3 µm−2) | Mean Thickness (µm) | Substratum Coverages (%) | |||
|---|---|---|---|---|---|---|
| None | 25.0 µg/mL | None | 25.0 µg/mL | None | 25.0 µg/mL | |
| S. aureus | 43.02 ± 2.4 | 6.11 ± 0.6 | 46.38 ± 3.1 | 11.36 ± 1.1 | 100 ± 0.8 | 8.01 ± 1.2 |
| E. coli | 40.80 ± 1.9 | 9.01 ± 1.0 | 39.42 ± 1.1 | 16.40 ± 0.4 | 100 ± 0.4 | 12.4 ± 2.1 |
Disclaimer/Publisher’s Note: The statements, opinions and data contained in all publications are solely those of the individual author(s) and contributor(s) and not of MDPI and/or the editor(s). MDPI and/or the editor(s) disclaim responsibility for any injury to people or property resulting from any ideas, methods, instructions or products referred to in the content. |
© 2022 by the authors. Licensee MDPI, Basel, Switzerland. This article is an open access article distributed under the terms and conditions of the Creative Commons Attribution (CC BY) license (https://creativecommons.org/licenses/by/4.0/).
Share and Cite
Rajamohan, R.; Raorane, C.J.; Kim, S.-C.; Lee, Y.R. One Pot Synthesis of Copper Oxide Nanoparticles for Efficient Antibacterial Activity. Materials 2023, 16, 217. https://doi.org/10.3390/ma16010217
Rajamohan R, Raorane CJ, Kim S-C, Lee YR. One Pot Synthesis of Copper Oxide Nanoparticles for Efficient Antibacterial Activity. Materials. 2023; 16(1):217. https://doi.org/10.3390/ma16010217
Chicago/Turabian StyleRajamohan, Rajaram, Chaitany Jayprakash Raorane, Seong-Cheol Kim, and Yong Rok Lee. 2023. "One Pot Synthesis of Copper Oxide Nanoparticles for Efficient Antibacterial Activity" Materials 16, no. 1: 217. https://doi.org/10.3390/ma16010217
APA StyleRajamohan, R., Raorane, C. J., Kim, S.-C., & Lee, Y. R. (2023). One Pot Synthesis of Copper Oxide Nanoparticles for Efficient Antibacterial Activity. Materials, 16(1), 217. https://doi.org/10.3390/ma16010217

